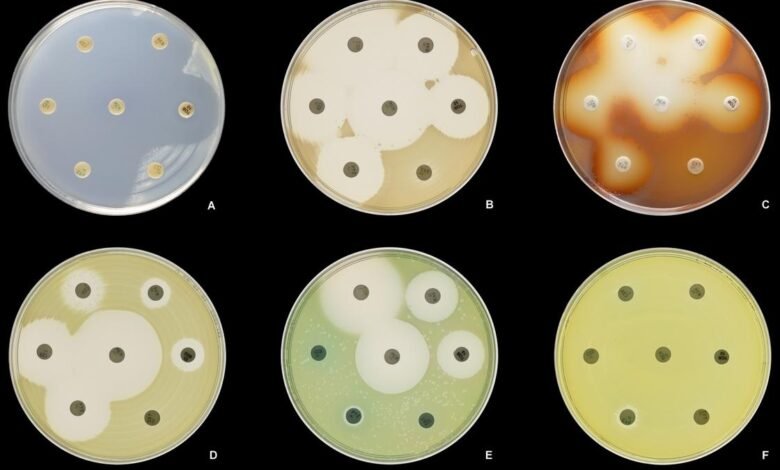

Um Jin batido fornece uma bactéria fatal de seu golpe
“O que é verdade é a favor Mostre o frio É verdade para o elefante. “
Significava os mesmos mecanismos básicos da biologia molecular, como síntese de proteínas, repetição de DNA e metabolismo celular, por bactérias e elefantes.
Em seu comentário, os Monods costumavam ter a visão de Bird sobre a biologia. Se você aumentar o suficiente, as células bacterianas podem ser jeans idênticas – e até da mesma colônia – completamente diferentes um do outro. Uma célula pode expressar um gene específico em um nível alto, enquanto a outra pode expressá -la em um nível baixo ou de todo. Cada bactéria continua a transferir o nível de sua expressão para seus filhos em um processo chamado herança de Lagini. Tais diferenças entre as células idênticas e os organismos, caso contrário, são chamados de efeito efetivo.
A eficácia de uma estratégia de sobrevivência usada por um organismos de células para se adaptar a condições ambientais voláteis.
Agora, uma equipe de pesquisadores, liderada por cientistas do Helmhultz Infection Research Center na Alemanha, informou que um gene está em bactérias. Pseudomonas aeruginosa A expressão batida aparece.
Isso é importante porque P. Aeruginosa São as causas de doenças oportunistas e mortais. A maioria das vítimas de combustão se rende ao ensino médio P. Aeruginosa Infecções. É uma das principais causas de inflamação da córnea e infecção ocular, pois afeta o cateter urinário. Infecções hospitalares P. Aeruginosa É famoso por antibióticos. Pesquisadores e médicos estão interessados em entender o que torna as bactérias muito mortais – o novo estudo abre a porta em direção a esse objetivo.
Os pesquisadores relataram que a expressão diferencial de Glpd O gene em células individuais de P. Aeruginosa Foi associado a diferenças na capacidade das bactérias de causar doenças, ou seja, suas propriedades patogênicas. Os resultados foram relatados em Os fatos da Academia Nacional de Ciências.
Siga a expressão genética
Genoma P. Aeruginosa Ele contém aproximadamente 6000 genes. Quando o gene é expresso, o RNA correspondente é feito. Este RNA é como textos. Pense neles como uma geração de gene. A célula carrega esse RNA nas fábricas de fabricação de proteínas chamadas ribossomos. Há informações usadas do RNA para costurar aminoácidos juntos em diferentes seqüências para tornar a proteína correspondente a esse gene.
Muitos genes produzem relativamente poucos textos. Vamos chamá -los de genes de baixa expressão (pernas). Por outro lado, genes de alta expressão (HEGs) produz muitos textos – em alguns casos de 100x a 10.000x a mais.
Em geral, há menos contraste nos números de texto quando a HEG é expressa na perna expressando. Embora a perna em uma célula possa expressar uma cópia, ela pode expressar em outra célula de 30, portanto, essa é uma faixa de 30x. Mas para o HEGS, o grupo 30X é improvável.
No novo estudo, os pesquisadores analisaram mais de 300 P. Aeruginosa Saldos para todos os textos que eles fizeram de seus genes. Eles descobriram isso embora Glpd O Jin Hing era a diferença no número de textos P. Aeruginosa As células que fizeram mais do que as outras HEGs eram. A descoberta sugeriu que Glpd O abraço de Jin pode estar em algumas células e suas pernas em outras.
Para explorar essa possibilidade, a equipe fundiu o setor de DNA que regula a expressão Glpd O gene com um gene produz proteína fluorcente verde (GFP). em qualquer momento Glpd O gene foi expresso e a célula também fabricou a proteína GFP, que brilha sob a luz. Dessa forma, os pesquisadores tinham um pequeno peb de óptica verde claro Glpd O gene foi expresso. A equipe também usou uma variável de curto prazo do GFP para fazer o sinal refletir com mais precisão a expressão generosa no tempo real.
Flutuação
Apenas uma pequena parte das células com gene de fusão acendeu e manteve uma condição “on” por um longo período de tempo. Mais importante, quando uma célula realmente iluminou até duas partes, uma das células da filha também acendeu, mas a outra não. Em alguma genealogia, a equipe descobriu que a habilidade “on” era transferida para até cinco gerações.
Na genealogia que desceu de uma célula que não iluminava, o IE estava “fora”, cerca de 5-6 % das células da filha se transformou aleatoriamente em “On”. Em metade desses casos, a situação estava “em curto prazo. Na outra metade, continuou como se a célula tivesse descendente do antecessor “Ali”.
Finalmente, mais células estavam “ligadas” quando a glicerina estava presente. Isso é esperado desde então P. Aeruginosa Bactérias são usadas Glpd O gene para aproveitar a glicerina.
Grande teste de mariposa
Grandes larvas de mariposa de cera (Galleria MilonellaParasitas de mel. Os cientistas usam larvas como modelo para estudar como as infecções bacterianas se desenvolvem e se espalham. Também no novo estudo, os pesquisadores atingiram as larvas maiores de traça de cera P. Aeruginosa Bactérias – mas antes de fazê -las, eles removeram Glpd Jin primeiro. Os pesquisadores descobriram que estes P. Aeruginosa As bactérias tiveram uma diminuição significativa na matança de larvas em comparação com as bactérias contendo gene adequado.
Este foi um sinal de que uma expressão Glpd O gene estava associado à capacidade das bactérias na infecção.
Os pesquisadores assumiram que a interação P. Aeruginosa Com as células em corpos de mamíferos (incluindo humanos), eles também podem estar associados ao mais alto Glpd para expressar. Para testar isso, a equipe implantou e afetou células imunes P. Aeruginosa Bactérias que contêm GFP. Os membros da equipe descobriram que as bactérias que entram em contato com as células do bacharelado no sistema imunológico do mouse estão desaparecendo mais, e isso significa Glpd Foi expresso mais.
Jogar
Variedade nos níveis de expressão de Glpd A expressão era clara mesmo em pequenos grupos de cerca de 10 a 50 células. Dado que as células que produziram mais Glpd Os textos foram melhores no movimento de infecções no movimento que sugeria que a infecção pudesse começar mesmo por um pequeno grupo.
Os pesquisadores também escreveram em seu artigo, “vários níveis de Glpd Expressão … pode ser uma estratégia … para o sucesso P. Aeruginosa Como uma enfermeira oportunista. “
Intuitivo, essa diferença pode prevenir medicamentos P. Aeruginosa Por ser o flagelo, está atualmente em hospitais.
O DP Kasbekar é um mundo aposentado.
Publicado 21 de agosto de 2025 05:30